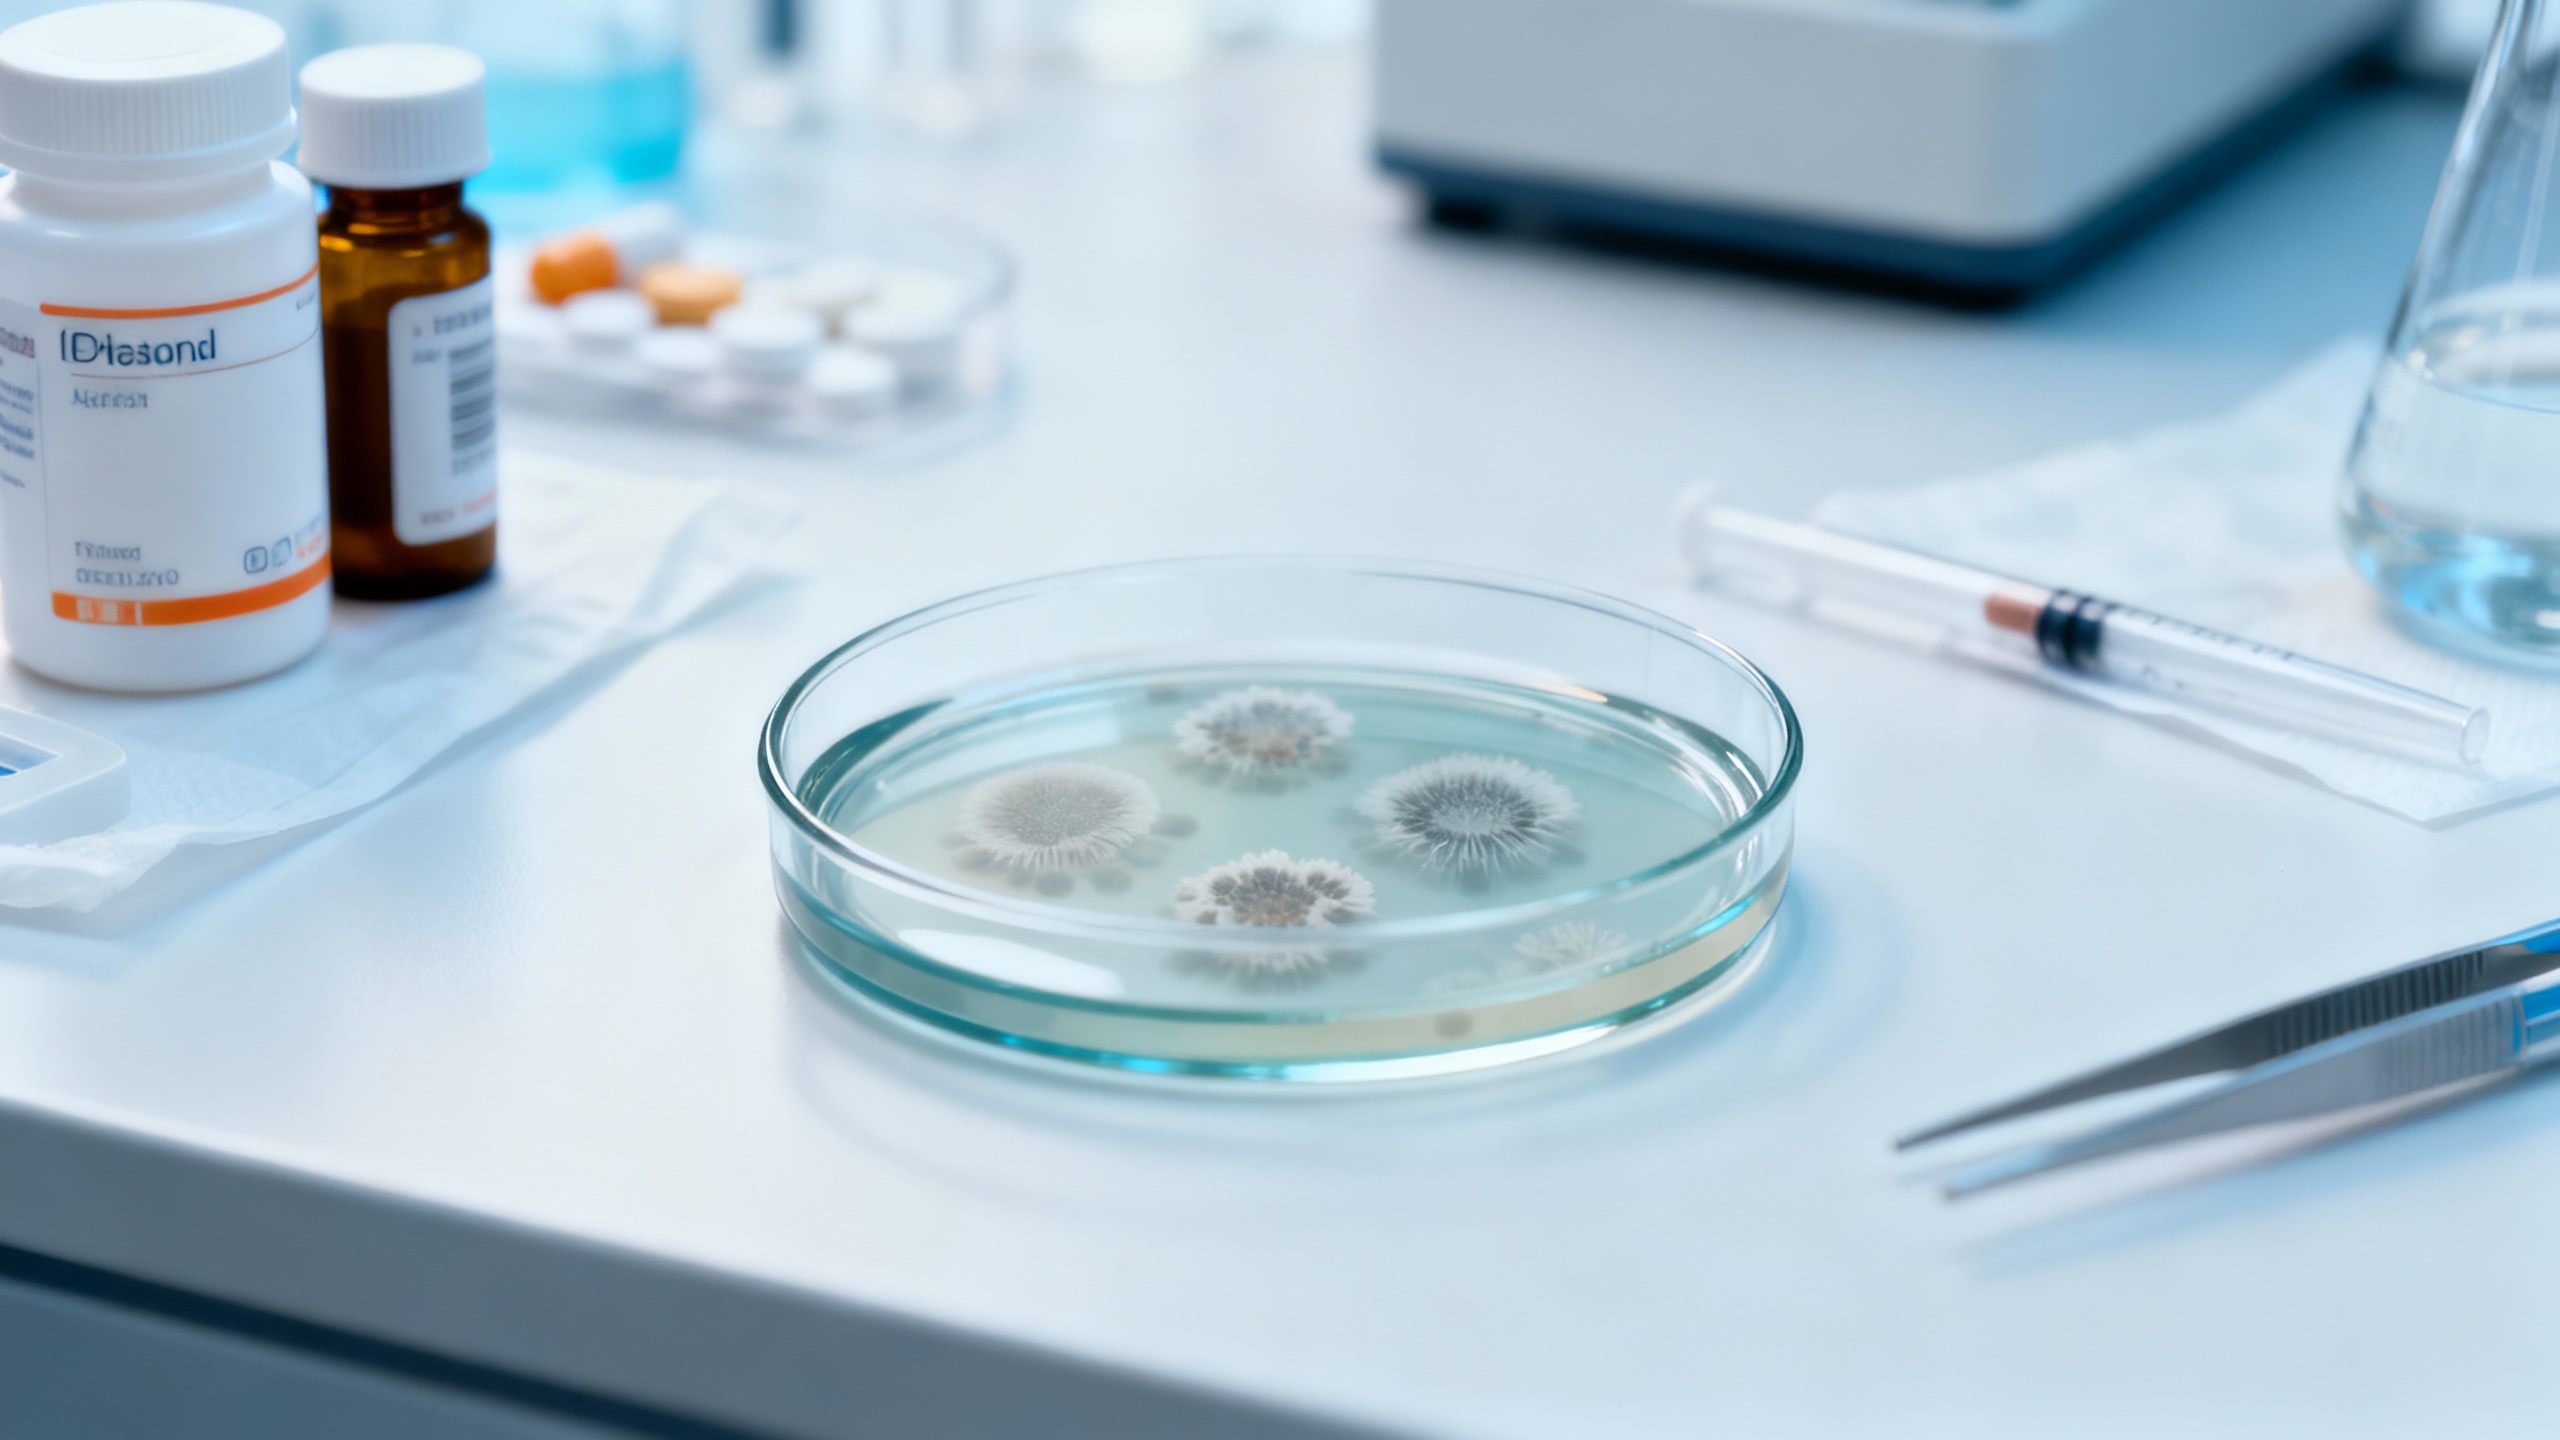
Featured image for Modern Prescription Medications: Success Rates in Treating Nail Fungus
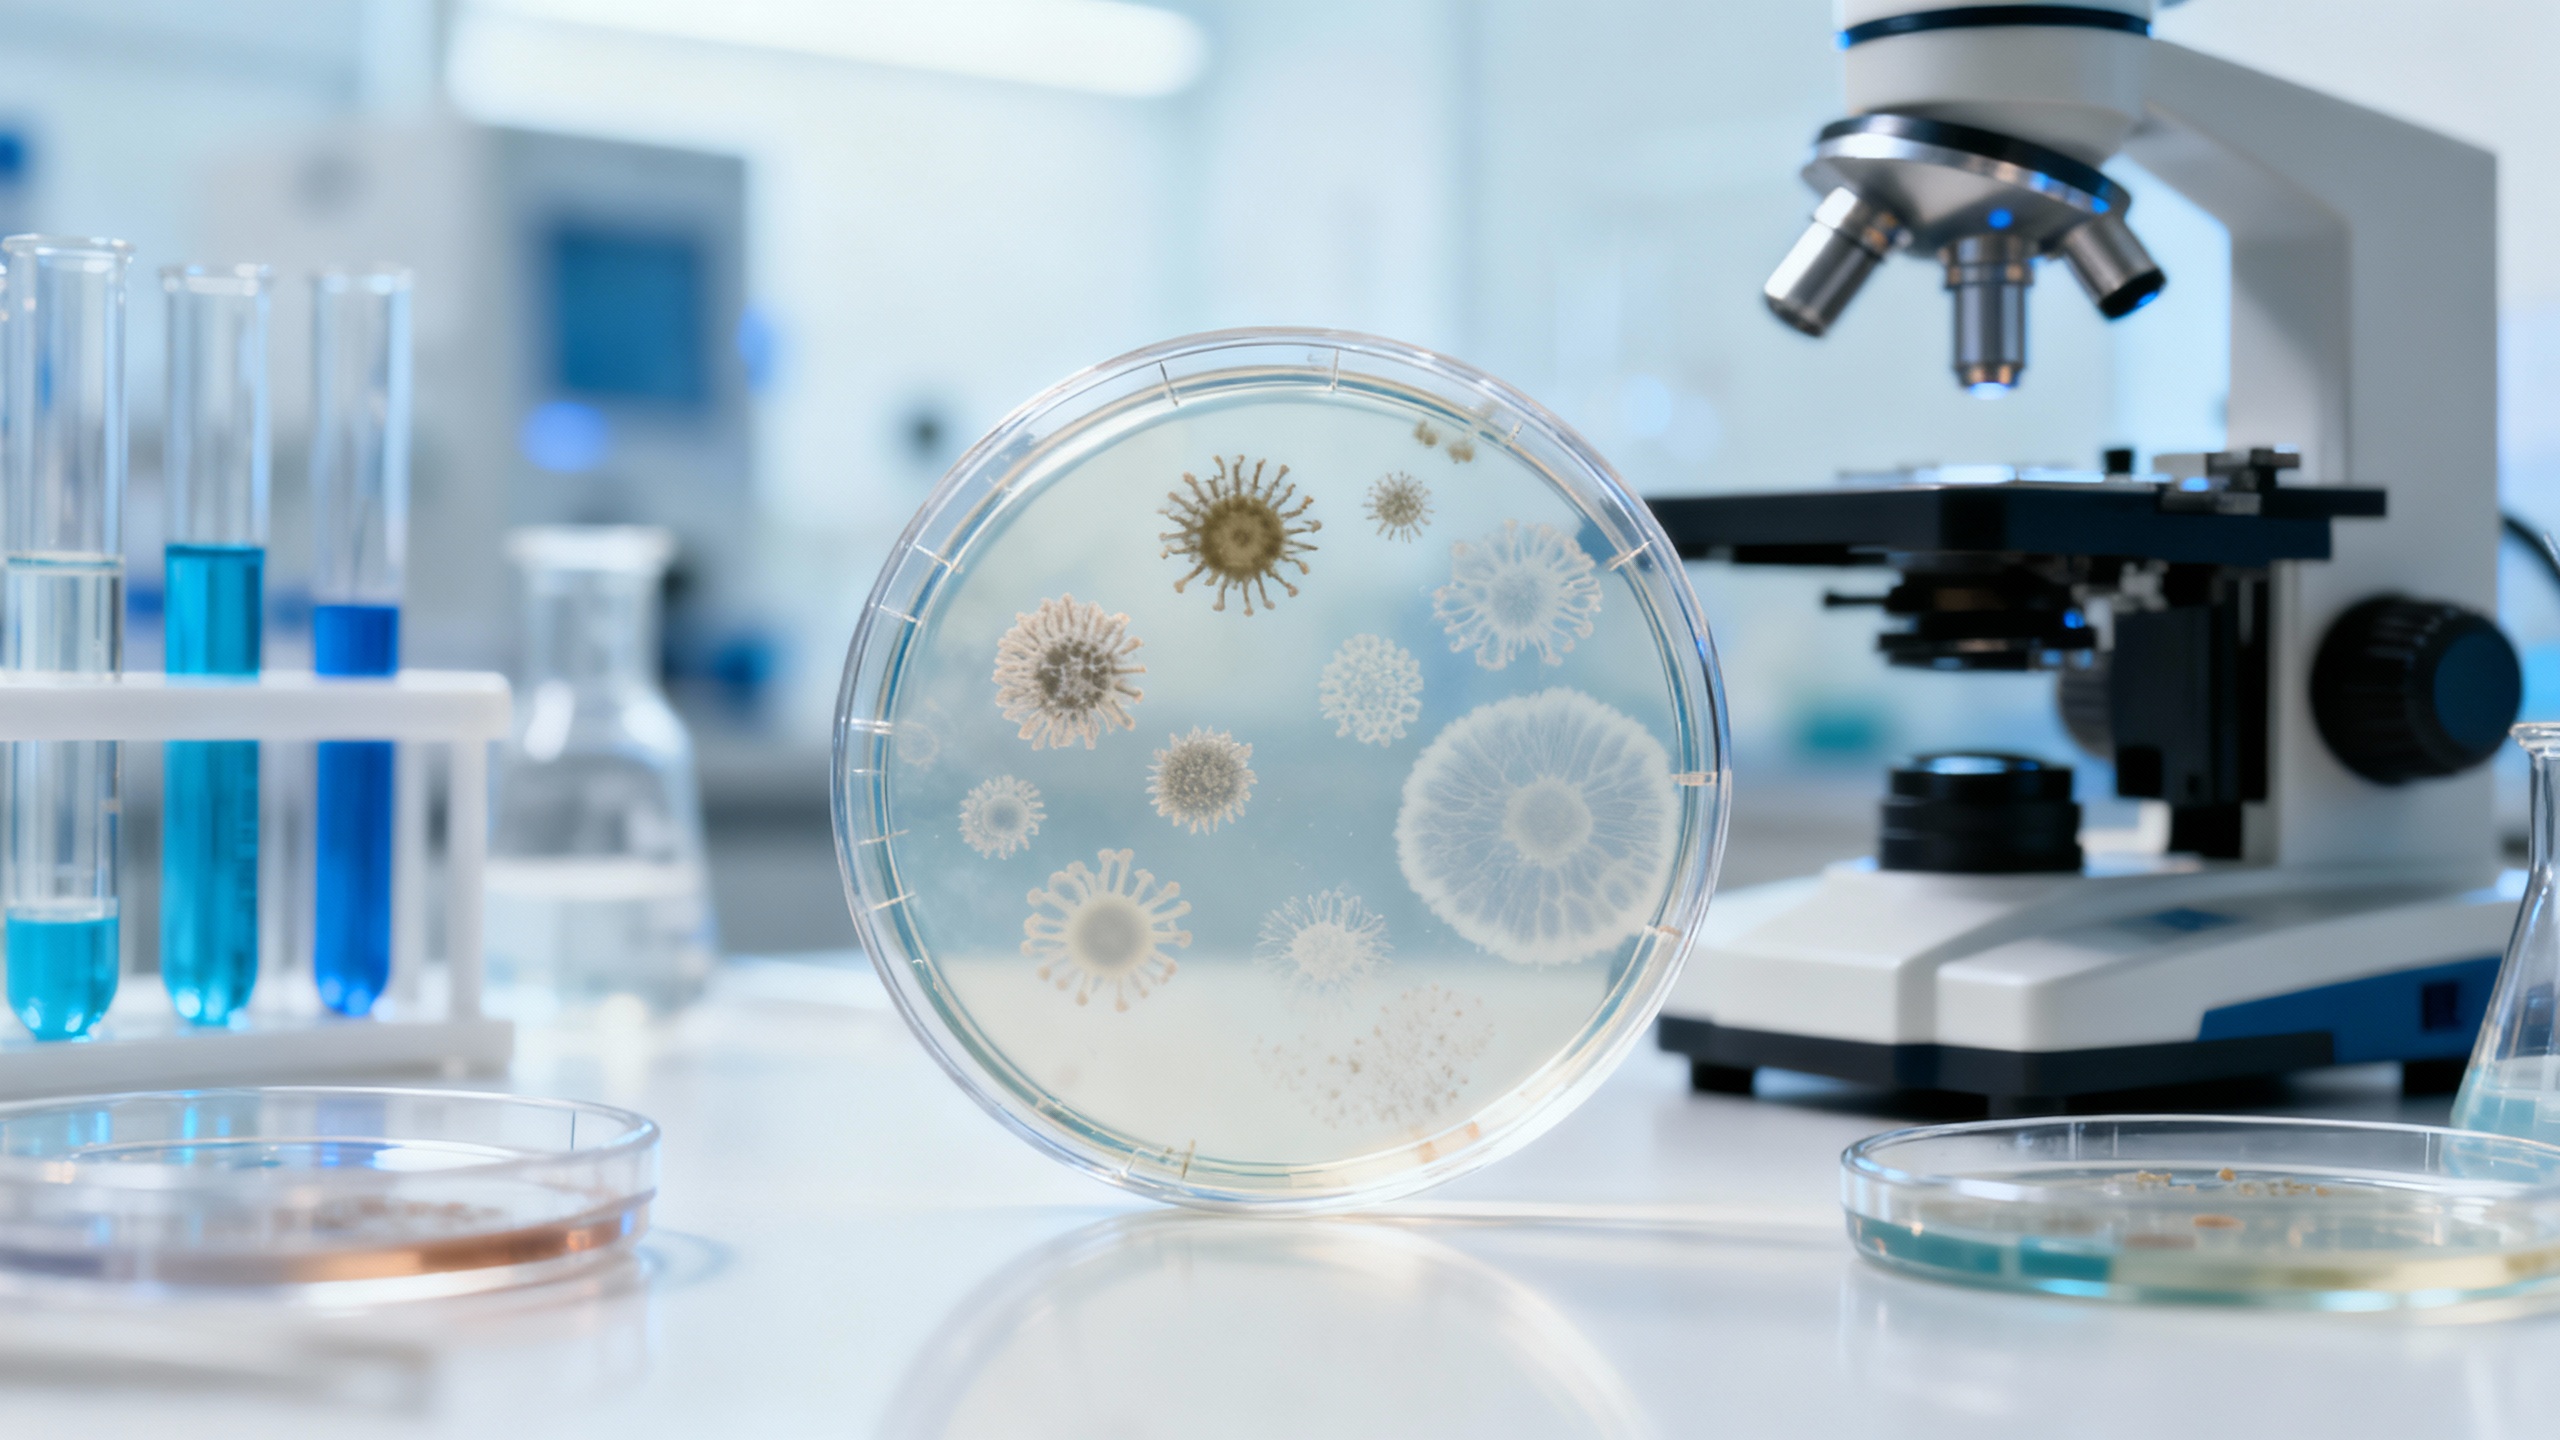
Featured image for Are Over-the-Counter Antifungal Creams Effective? A Deep Dive into the Research

29 January 2026
Essential 6 Products That Help Reduce Discomfort

Six essential products chosen to relieve different kinds of discomfort, from skin irritation to muscle soreness. Minor aches, stinging skin, and everyday soreness can make routine tasks harder than they need to be. Luckily, several targeted…
Continue reading